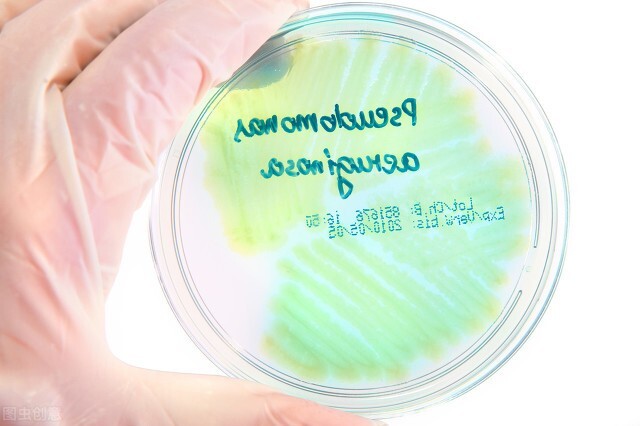
尿道口出现脓性分泌物，是淋病吗？

淋病是由于淋病奈瑟菌感染引起的性传播性疾病,人是淋病奈瑟菌的唯一天然感染宿主。淋病是最常见的性传播疾病之一。

尿道口出现脓性分泌物,是淋病吗?
淋病可引起泌尿生殖道感染和泌尿生殖道外感染。泌尿生殖道感染包括尿道炎、宫颈炎、盆腔炎等。泌尿生殖道外感染包括咽炎、眼结膜炎、直肠炎及播散性淋病引起菌血症、皮肤损害、关节炎等。

淋病导致的尿道炎,临床症状表现为尿频、尿急、尿痛以及尿道口出现脓性分泌物。对于男性,如果尿道口出现了脓性分泌物,有可能是淋病引起,但是也要与沙眼衣原体性尿道炎等感染性疾病鉴别。

女性得了淋病,也会出现脓性分泌物吗?
女性得了淋病,会出现子宫颈红肿、阴道分泌物增多和排尿困难,另外还会引起盆腔炎以及其他泌尿生殖道外感染。因此,女性得了淋病,主要是阴道分泌物增多,是否出现脓性分泌物也不一定。

尿道口出现脓性分泌物,怎么办?
1.如果有高危*行为性**史(不安全*行为性**、多*伴侣性**等),需要警惕是否有淋病奈瑟菌感染。
2.建议尽早到医院就诊,明确诊断。只有诊断清楚,才能对症下药。

3.怀疑淋病时,需要进行病原学检查,在门诊医生取尿道分泌物进行显微镜镜检和细菌培养。因此,建议有症状时及时取分泌物做检查。
4.淋病是可以治愈的,越早治疗,效果越好。因此,出现症状时,不用害怕看医生,要尽早、彻底地治疗。
5.淋病患者的伴侣也是需要一起治疗的。
欢迎点赞和关注哦!关注梁医生,收获更多健康知识☀️